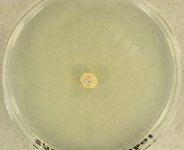
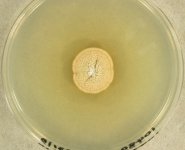

Search Details
| UAMH Number: | 10480 |
|---|---|
| Species Name: | Trichophyton interdigitale |
| Type: | |
| Synonyms: | Bodinia abissinica / Epidermophyton interdigitale / Favotrichophyton abissinicum / Kaufmannwolfia interdigitalis / Microides interdigitalis / Sabouraudiella interdigitalis / Sabouraudites interdigitalis / Trichophyton abissinicum / Trichophyton batonrougei / Trichophyton candelabrum / Trichophyton krajdenii / Trichophyton mentagrophytes var. batonrougei / Trichophyton mentagrophytes var. interdigitale |
| Taxonomy: | FUNGI Ascomycota, Eurotiomycetes, Onygenales, Arthrodermataceae |
| Strain History: | Ghannoum, M. -> R. Rennie (MY 4657) -> UAMH |
| Substrate: | skin | Location: | USA Ohio, Cleveland, University Hospitals of Cleveland (GEO: 41.506,-81.607) |
| Isolator: | M. Ghannoum |
| Isolation Date: | 2004 |
| Date Received: | 2004-09-14 |
| Characters: | FUNGUS RESISTANCE TESTING susceptibility testing for antifungals, Modified CLSI M38-A, broth microdilution method - Ghannoum et al., J Clin Microbiol. 2006 Dec; 44(12): 4353-4356. // MOLECULAR SYSTEMATICS Beta-tubulin sequence confirmed the identity of this strain as T. interdigitale - UAMH/ W. Shaheed (Click for publications citing UAMH 10480) |
| Compounds: | |
| Cross Reference: | ATCC MYA-4439 |
| Collections: | Living Strains; Dried Herbarium Material |
| Pathogenic Potential: | Human: yes | Animal: no | Plant: no |
| Biosafety Risk Group: | RG2 (check the PHAC ePATHogen Risk Group Database for updates) |
| Regulatory Requirements: | Canadian requesters must provide PHAC Pathogen and Toxin License Number (see: https://www.canada.ca/en/public-health/services/laboratory-biosafety-biosecurity/licensing-program.html) and a CFIA Written Authorization for transfer (http://www.inspection.gc.ca/plants/plant-pests-invasive-species/directives/date/d-12-03/eng/1432656209220/1432751554580#app2) prior to shipment. International requesters must provide all legally required importation documentation prior to shipment. This strain is not available for shipment to Cuba, the Democratic People's Republic of Korea, Iran or Syria. Plant pathogenicity status may be verified by using the USDA Agricultural Research Service (ARS) Fungal Database |
| MycoBank ID: | 119122 |
| Sequences: | >UAMH10480_KJ606209_bTub CTAGCTTTCCCCCTGTCCATCACTTCCCCTCTATTTGTGCCCGAAAAACACGACACGGTCTGCACAGGCCAAGAAAGGGGGGGAGGCGAGGGCCACCACACGACCACGTCCCAGCGTGAAGGGGACAGGCTTCGAGTTTCACAATTCTCGCATAGCGAGCTTCGAGCATCAGGCTAACGTGCATTTATCGTATAGGTCCATCTCCAAACCGGCCAATGTGTAAGCTTTGATCGTTCCCTGGTTCGTTCTCAGGTACCCGTTTGAGTTAACAATTGTTCGACATTAGGGTAACCAAATTGGTGCTGCTTTCTGGTGAGCATTCATGCGTTGCAGCATAATTGTATATTTCGTGTCGAGTTGTTACTGACTTGGTTTACAGGCAAACCATTGCTGGTGAGCACGGTCTCGATGGATCCGGCCAGTGAGTGATTCTGCAAGAAAAAGTTCCGGTCTTGAGGGACTTGAACGTTGACAACTGGGATTTCTATAGCTACACCGGATCTTCTGACCTCCAATTGGAGCGCATGAATGTCTACTTCAACGAGGTGTGCACGACCAAGACCCTTCCCTTCAGCAGCATACTAACTCATTGGAGGCAAAGGCCTCAAGCAAAAAATACGTTCCCCGTGCGGTTCTTGTTGATCTTGAGCCCGCCGCTCTCGATGCTGTCCGCGCCGGTCCTTTTGGTCAGCTCTTCCGCCCCGATAACGTCGTCTTCGGTCAGTCTGGTGCCGGAAACAACTGG >UAMH10480_KJ606161_LSU ATATCAATAAGCGGAGGAAAAGAAACCAACAGGGATTGCCCCAGTAACGGCGAGTGAAGCGGCAAGAGCTCAAATTTGAAATCTGGCCTCCCCCGGGGGCCCGAGTTGTAATTTGCAGAGGATGCTTCGGGTGCGGCCGCCGTCTAAGTTCCTTGGAACAGGACGTCAGAGAGGGTGAGAATCCCGTCTTGGGCGGGCGGTCCGCGCCCGTGTGAAGCTCCTTCGACGAGTCGAGTTGTTTGGGAATGCAGCTCTAAGCGGGTGGTAAATTTCATCTAAAGCTAAATATTGGCCGGAGACCGATAGCGCACAAGTAGAGTGATCGAAAGGTTAAAAGCACCTTGAAAAGGGAGTTAAACAGCACGTGAAATTGTTGAAAGGGAAGCGCTTGCGGCCAGACTCGGGGGCGGGGTTCAGCGGGTGCTCGTCGCCCGTGTATTCCTCGTCTCCCGGGCCAGCATCAGTTTCGACGGCCGGTCAAAGGCCCCCGGAATGTGTCGTCTCTCGGGACGTCTTATAGCCGGGGGTGCAATGCGGCCCGTCGGGACTGAGGAACGCGCTCCGGCTCGGATGCTGGCGTAATGGCCGTAAGCGGC >UAMH10480_FJ746658_SSU-LSU AGGTTTCCGTAGGTGAACCTGCGGAAGGATCATTAGCGCGCAGGCCGGAGGCTGGCCCCCCACGATAGGGCCAAACGTCCGTCAGGGGTGAGCAGATGTGCGCCGGCCGTACCGCCCCATTCTTGTCTACATTACTCGGTTGCCTCGGCGGGCCGCGCTCTCCCAGGAGAGCCGTTCGGCGAGCCTCTCTTTAGTGGCTAAACGCTGGACCGCGCCCGCCGGAGGACAGACGCAAAAAAATTCTTTCAGAAGAGCTGTCAGTCTGAGCGTTAGCAAGCAAAAATCAGTTAAAACTTTCAACAACGGATCTCTTGGTTCCGGCATCGATGAAGAACGCAGCGAAATGCGATAAGTAATGTGAATTGCAGAATTCCGTGAATCATCGAATCTTTGAACGCACATTGCGCCCCCTGGCATTCCGGGGGGCATGCCTGTTCGAGCGTCATTTCAGCCCCTCAAGCCCGGCTTGTGTGATGGACGACCGTCCGGCGCCCCCGTCTTTGGGGGTGCGGGACGCGCCCGAAAAGCAGTGGCCAGGCCGCGATTCCGGCTTCCTAGGCGAATGGGCAACAAACCAGCGCCTCCAGGACCGGCCGCCCTGGCCTCAAAATCTGTTTTATACTTATCAGGTTGACCTCGGATCAGGTAGGGATACCCGCTGAACTTAAGCATATCAATAAGCG >UAMH10480_KJ606113_SSU-LSU GGTTTCCGTAGGTGAACCTGCGGAAGGATCATTAGCGCGCAGGCCGGAGGCTGGCCCCCCACGATAGGGCCAAACGTCCGTCAGGGGTGAGCAGATGTGCGCCGGCCGTACCGCCCCATTCTTGTCTACATTACTCGGTTGCCTCGGCGGGCCGCGCTCTCCCAGGAGAGCCGTTCGGCGAGCCTCTCTTTAGTGGCTAAACGCTGGACCGCGCCCGCCGGAGGACAGACGCAAAAAAATTCTTTCAGAAGAGCTGTCAGTCTGAGCGTTAGCAAGCAAAAATCAGTTAAAACTTTCAACAACGGATCTCTTGGTTCCGGCATCGATGAAGAACGCAGCGAAATGCGATAAGTAATGTGAATTGCAGAATTCCGTGAATCATCGAATCTTTGAACGCACATTGCGCCCCCTGGCATTCCGGGGGGCATGCCTGTTCGAGCGTCATTTCAGCCCCTCAAGCCCGGCTTGTGTGATGGACGACCGTCCGGCGCCCCCGTCTTTGGGGGTGCGGGACGCGCCCGAAAAGCAGTGGCCAGGCCGCGATTCCGGCTTCCTAGGCGAATGGGCAACAAACCAGCGCCTCCAGGACCGGCCGCCCTGGCCTCAAAATCTGTTTTATACTTATCAGGTTGACCTCGGATCAGGTAGGGATACCCGCTGAACTTAAGCATATCAATAA |
IMAGES: